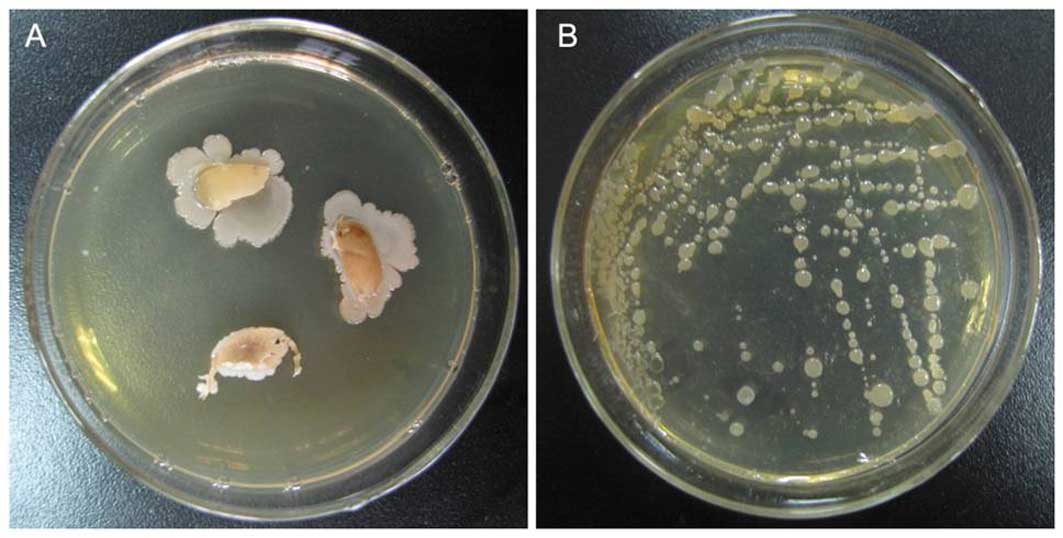

Introduction
Despite recent advances in our knowledge of the
molecular pathogenesis and targeted therapy of cancer, it remains
one of the most malignant diseases threatening human health and
quality of life. The World Health Organization has defined cancer
as one of the top ten leading causes of mortality worldwide
(1). Chemotherapy, combined with
radiotherapy and surgery, is the main strategy for anticancer
treatment. However, this strategy has limitations, including
multidrug resistance and severe side effects in the clinical
application, therefore impelling the search for new anticancer
drugs with greater therapeutic efficiency or fewer side effects.
Recently, natural products have gained increasing attention from a
therapeutic point of view and have become the most consistently
successful source of potential new drugs (2). Endophytic bacteria are one chief
source of natural anticancer products, and are well-known for being
producers of vast bioactive anti-cancer compounds, including
anthracyclines, glycopeptides, aureolic acids, anthraquinones,
enediynes, antimetabolites, carzinophilin and mitomycins (3–5).
Endophytic bacteria are beneficial microbes that
reside in living plant tissues, mainly in the intercellular space
and inside vascular tissues, without either doing harm to the host
or providing any benefit to other microbial residents (6–8). The
bacteria ubiquitously colonize and persist on the inner organs of
plants, including the leaves, stems, seeds, tubers, fruits, ovules
and, in particular, the roots, during their life-cycles (9–11).
Although the interaction between these microorganisms and their
respective host-plant is not, as yet, fully understood, progress
has been made in the application of such bacteria as their
metabolites have diverse biological functions. In total, >129
species representing >54 genera, including the Bacillus,
Pseudomonas and Agrobacterium genera, have been
isolated from agricultural plants and macrophytes (6,12,13).
To date, an increasing number of bacterial endophytes have been
idenitified in medicinal herbs commonly used as traditional Chinese
medicines (14–16).
The plant Ophiopogon japonicus (Thunb)
Ker-Gawl, an evergreen perennial medicinal herb, is widely
distributed in South-East Asia, particularly in mainland China
(Sichuan and Zhejiang provinces) (17). Its tuberous roots (known as
Mai-dong in China) have been extensively used in traditional
Chinese medicine to treat acute and chronic inflammatory diseases,
as well as cardiovascular diseases, for thousands of years, as
originally recorded by the ‘Shennong Materia Medica’ (Shen Nong Ben
Cao Jing) (18–20), in the Eastern Han Dynasty of China
(24–220 AD) and officially listed in the China Pharmacopeia
(21). Phytochemical studies have
revealed that O. japonicus is rich in the polysaccharides,
homoisoflavonoids and saponins to which Mai-dong’s medicinal
activities are largely ascribed (22–25).
Recently, the majority of studies have focused on these bioactive
compounds and their therapeutic functions, while little attention
has been paid to the endophytes of O. japonicas, with only
one study concerned with the isolation of actinomycetes from this
herb (26). In the majority of
plants, endophytes inhabit roots more easily than the aboveground
tissues (27). In this regard,
Mai-dong, the roots of O. japonicas, may be an
overlooked promising niche for endophytic bacteria that warrants
further investigation.
In order to exploit the untapped microbial resources
capable of producing useful mebabolites, we isolated a variety of
endophytic fungi and bacteria in our preliminary study (28), and then discovered a Gram-positive
bacteria strain with sticky colonies (Fig. 1). Further study confirmed the
existence of exopolysaccharides in the colonies which might have
resulted in the sticky characteristics. However, the species this
strain belongs to and whether its exopolysaccharides possess useful
biological activities remains unknown. Therefore, the present study
was conducted to identify the endophytic bacteria strain and
evaluate the bacterial polysaccharides for their antitumoral
activity against gastric tumors.
Materials and methods
Collection and preparation of plant
material
The dried tuberous roots of O. japonicas
(Mai-dong) were collected from its trueborn cultivating area
in Hangzhou (Zhejiang, China), and then identified and
authenticated on the basis of its botanical characteristics. A
voucher specimen (No. Md100912) was deposited at the College of
Life Science, Zhejiang Chinese Medical University, Zhenjiang,
China.
For surface sterilization, the fresh tuberous roots
were thoroughly washed in running tap water to remove adhered
epiphytes and soil debris, followed by washing them three times in
sterile distilled water. Subsequent to being dried in sterile
conditions, the root surfaces were sterilized by sequential
immersion in 75% (v/v) ethanol for 5 min and 0.1% (v/v) mercury
bichloride solution for 5 min. The sterilized roots were rinsed
three times with sterile distilled water and excess surface
sterilant was evaporated in a hot-air oven. To confirm the success
of the surface sterilization, 100 μl aliquots of the last
washing solution were plated on Luria-Bertani (LB) media; a lack of
bacterial colony growth was consequently observed on the
plates.
Isolation of endophytic bacteria
The root samples were sectioned into 4–6-mm slabs
using a sterile scalpel and then transferred onto LB plates,
followed by incubation at 25±2°C for 7–14 days to allow the growth
of endophytic bacteria from the sections. The colonies were
isolated and sequentially subcultured onto fresh LB plates for
further purification. The purified colonies on the last LB plate
were transferred into 5 ml liquid LB medium in conical flasks
maintained at 37°C and agitated at 39 × g for 12 h. Subsequently,
each suspension was centrifuged at 3,914 × g for 1 min and the
deposits were dissolved in 1 ml TE buffer (1 M Tris-HCl, 0.5 M
EDTA; pH 8.0). Following further centrifugation at 3,914 × g for 1
min, the deposits were collected as isolated endophytic bacteria
and stored at −20°C prior to use.
DNA extraction and identification of
endophytic bacteria
The isolated endophytic bacteria were resuspended in
200 μl TE buffer with 50 μl lysozyme and then
incubated in a water bath at 37°C for 60 min with gentle agitation.
A total of 10 μl proteinase K was added to the suspension,
followed by incubation at 37°C for 30 min with gentle agitation.
The suspension was then supplemented with 40 μl 10% SDS and
incubated at 37°C for 30 min with gentle agitation. Subsequent to
being mixed with 100 μl 5 M NaCl and 200 μl 3 M
sodium acetate solutions, an equal volume of chloroform:isoamylol
was added and then the suspension was gently shaken. Following
being left to stand at room temperature for 5 min, the mixture was
centrifuged at 2,609 × g for 10 min and the supernatant was
transferred into precooled isopropanol and maintained for 5 min.
Following centrifugation at 3,914 × g for 10 min, the deposit was
washed with 1 ml 70% ethanol and dried by evaporation at room
temperature. The final deposit was dissolved with 30 μl
high-salt TE buffer and collected as extracted DNA for the
following analysis.
The extracted DNA was electrophoresed in 1% (w/v)
agarose gel, stained with ethidium bromide and UV-visualized. To
determine the 16S rDNA gene sequence, PCR was conducted using the
universal primers (forward, 5′-AGAGTTTGA TCCTGGCTCAG-3′; reverse,
5′-AAGGAGGTGATCCAG CCGCA-3′). PCR amplification consisted of an
initial denaturation at 94°C for 5 min followed by 30 cycles
(denaturation at 94°C for 1 min, annealing at 55°C for 1 min and
extension at 72°C for 2 min) and a final extension at 72°C for 8
min. Amplified DNA was purified using a Takara agarose gel DNA
purification kit (Takara Biotechnology Co., Ltd., Dalian, China)
and sequenced by Takara Biotechnology Co., Ltd. The 16S rDNA
sequence was subjected to BLAST analysis with the NCBI database and
aligned by using the multiple sequence alignment program CLUSTAL W
(43). A phylogenetic analysis was
performed using CLUSTAL X (44) and
MEGA 4.0 (45) software, based on
the neighbor-joining (46),
maximum-likelihood (47) and
maximum-parsimony methods (48).
Extraction and quantification of
exopolysaccharides from endophytic bacteria
The isolated endophytic bacteria were incubated in
liquid LB medium and agitated at 37°C for 48 h, followed by 10 min
of boiling for enzyme inactivation. Following centrifugation at
1,292 × g for 30 min, the supernatant of the bacteria suspension
was decolored with active carbon in a water bath at 40°C for 30
min, and then deproteinized using the Sevag method. Following
subsequent centrifugation at 1,292 × g for 30 min, the supernatant
was concentrated by evaporation and mixed with a 3-fold volume of
95% ethanol. The mixture was maintained overnight at 4°C, then
centrifuged and its deposit dissolved with double distilled water.
Following the final centrifugation, the supernatant was collected
as bacteria exopolysaccharides following dialysis against double
distilled water for 24 h. The content of the polysaccharides was
measured using a phenol-sulfuric acid colorimetric method (49), with glucose as the reference. The
concentration of polysaccharides was calculated as the
polysaccharide content of extraction (mg) divided by the volume of
the last liquid LB medium (3,600 ml).
Tumor cell lines and culture
condition
Human gastric carcinoma cell lines (MC-4 and
SGC-7901) were provided by the Zhejiang Provincial Center for
Disease Control and Prevention (Zhejiang CDC; Hangzhou, China). The
MC-4 and SGC-7901 cells were cultured as described in our previous
study (38). The cultured cells
collected at the stage of logarithmic growth were detached using
0.25% trypsin and their viabilities were shown to be >98%, as
revealed using the Trypan blue exclusion test. A suspension of each
cell line containing 5×104 cells was pipetted into a
96-well flat-bottomed plate and maintained in a humidified
incubator at 37°C with 5% CO2 for 24 h.
Antitumor evaluation of the
exopolysaccharides
Samples of the extracted bacterial polysaccharides,
diluted with distilled water into three concentrations (30, 22 and
14 μg/μl), were added to each well of each cell line
respectively, followed by incubation for 18 h at 37°C with 5%
CO2. The polysaccharide-induced cell damage was
morphologically observed under a Leica DMIRE2 inverted fluorescence
microscope (Leica Microsystems Corp., Bensheim, Germany). The
inhibitory effects of the polysaccharides on MC-4 and SGC-7901 cell
proliferation were evaluated using a
3-(4,5-dimethylthiazol-2-yl)-2,5-diphenyltetrazolium bromide (MTT)
assay as described previously (38). MTT solution (10 μl/well, 5
mg/ml) was added to each well and the plate was incubated for 4 h
at 37°C. A total of 150 μl DMSO was added to replace the
supernatant in each well and the plate was gently agitated for 10
min for the dissolution of formazan crystals. The absorbance of
each well at 490 nm was measured by an ELISA plate reader (Wellscan
MK3; Thermo Labsystems, Helsinki, Finland). The cell viability of
each treated group was calculated as the percentage of the
untreated control group which was assumed to be 100%. The
cytotoxicity of the polysaccharides was expressed as the
IC50 (sample concentration causing 50% inhibition of
cell proliferation) and calculated by Bliss’s method. Three
replicates were conducted for the experiment.
Statistical analysis
All measurements are expressed as the mean ±
standard deviation and were subjected to one-way analysis of
variance (ANOVA), followed by Fisher’s least significant difference
(LSD) comparison. P<0.05 and P<0.01 were considered to
indicate statistically significant differences. All analyses were
performed using DPS software (Refine Information Tech. Co., Ltd.,
Hangzhou, China) (50).
Results and Discussion
Isolation and identification of
endophytic bacterium from Mai-dong
A Gram-positive bacterium, MD-b1, with sticky colony
characteristics was isolated from the inner section of
Mai-dong and confirmed as an endophyte when all surface
microbes on the plant were killed through surface sterilization. A
partial sequence of the 16S rDNA gene (1,500 bp) was identified and
deposited in GenBank at NCBI (Accession no. HM 160161). BLAST
analysis revealed that MD-b1 belonged to the genus Bacillus
and demonstrated the highest similarity of 99% with the Bacillus
amyloliquefaciens strain (Accession no. NR 041455). A
neighbor-joining dentrogram was constructed for the phylogenetic
analysis of this endophyte bacterium, as shown in Fig. 2.
Although numerous endophytes have been isolated from
traditional Chinese medicines (29), to the best of our knowledge, the
present study is the first with regard to the endophytic
microorganism isolated from the O. japonicas tuberous root
(Mai-dong). The finding that endophytes mostly colonize the
underground plant tissues, i.e., the root interior, was expected
and is in agreement with previous studies (30,31).
The root endophytic bacteria from the Bacillus genus,
including the isolated MD-b1 in the present study, are capable of
producing bioactive substances (e.g., mycosubtilin, iturin and
surfactin) with antifungal, antibacterial and biosurfactant
properties (14,32,33).
Besides their application in the areas of biocontrol and
agriculture, the medicinal use of metabolites from such endophytes
has gained increasing attention from a pharmaceutical perspective.
The only reported medicinal effect of the endophytic
Bacillus strains was antioxidation derived from their
production of extracellular enzymes, including amylase, cellulose,
pectinase and xylanase (34).
Exopolysaccharide production of
MD-b1
As a major class of natural products, metabolites
from microorganisms are one of the most reproducible and dependable
sources for the development of ‘first-in-class’ drugs (35). The sticky characteristics of the
MD-b1 colonies indicated that the MD-b1 were able to produce
metabolites consisting mainly of polysaccharides. Therefore, in the
present study, exopolysaccharides were extracted from this
endophytic bacterium through fermentation. The content of the
polysaccharides in the fermentation broth was 660 mg with a
concentration of 0.22 mg/ml. No matter how many of the
polysaccharides were biosynthesized by MD-b1, the large-scale
production of such metabolites was always achievable using the
conventional LB liquid media, indicating the potential scientific
and commercial implications for its applications. Polysaccharides
are a group of water-soluble bioactive compounds that have
attracted considerable interest due to their wide spectrum of
bioactivities and their low toxicity. The most common biological
functions of polysaccharides are associated with immune system
modulation, including antitumoral, antiviral and antioxidant
activities. It is noteworthy that the host plants that generate the
bioactive products have associated endophytes that are also able to
produce the same natural products (36). Considering the antitumoral activity
of the Mai-dong polysaccharides (37), the MD-b1-produced polysaccharides
are thereby expected to have the same activity against tumors.
Antitumoral activity of the
polysaccharides derived from MD-b1
Light microscopy was used to observe the
morphological changes to the tumor cells (MC-4 and SGC-7901). As
shown in Fig. 3A and B, the
untreated MC-4 and SGC-7901 cells displayed a normal shape with no
apoptosis, indicating the normal condition of these cells. However,
following treatment with MD-b1-derived polysaccharides at
increasing concentrations (14, 22 and 30 μg/μl), the
MC-4 and SGC-7901 cells were found to be damaged or dead with
evident cell morphological abnormalities (Fig. 3A1–3 and B1–3), indicating the
apoptosis-inducing effect of the polysaccharides against gastric
tumor cells. Cell apoptosis may occur with cell shrinkage or
collapse, membrane blebbing, boundary splitting or aggregation and
nuclei condensation or nucleus fragmentation (38). Additionally, MC-4 and SGC-7901
underwent increasing morphological changes with the increasing
polysaccharides concentrations, suggesting that the
apoptosis-inducing effect occurred in a dose-dependent manner. The
MTT assay also revealed a result consistent with this, where the
significant inhibitory effect of the MD-b1-derived polysaccharides
against the proliferation of the MC-4 and SGC-7901 cells was
identified. As expressed by the tumor cell viability, as well as
the IC50 estimates in Fig.
4, the polysaccharides exerted a concentration-dependent
inhibitory effect against the MC-4 and SGC-7901 cells with an
IC50 of 19.7 and 26.8 μg/μl, respectively.
Compared with the untreated controls, significant inhibition
(P<0.01) of the MC-4 and SGC-7901 cells was observed at the
polysaccharide concentrations of 14–30 μg/μl and
22–30 μg/μl, respectively (P<0.01). Together, the
antitumoral activity of the MD-b1-derived polysaccharides against
human gastric tumor cells in vitro was thereby confirmed for
the first time in the present study.
In recent years, gastric carcinoma has contributed
to the high mortality rate of cancer worldwide, attracting
increasing attention for the development of specific agents from
new sources of natural products. Cytotoxicity-based screening for
compounds with antitumoral activities has been previously proven to
be successful in the identification of clinically applied natural
anticancer products (39). In the
present study, we demonstrated the prominent in vitro
antitumoral activity of MD-b1-derived polysaccharides based on
cytotoxicity assays. This demonstrated the promising prospects of
such compounds in anticancer applications. The antitumor mechanism
may be associated with mitochondrial dysfunction leading to
mitochondrial potential loss of the tumor cells (40,41).
However, the low oral bioavailability of polysaccharides, caused by
their large molecular size and hydrophilic property, has limited
their therapeutic applications in the clinic. However, with the
co-use of absorption enhancers, such as sodium caprate, this
problem may currently be overcome (23). Further chemical analysis is required
to determine whether MD-b1-derived polysaccharides contain similar
components to Mai-dong polysaccharides, since these two
differently-sourced polysaccharides exhibit similar antitumoral
activities. A generally accepted theory regarding this issue has
suggested that the genetic recombination of the endophytes with the
host may have occurred in their evolutionary period (42), resulting in the possibility that
MD-b1-derived polysaccharides and Mai-dong polysaccharides
have the same origin. If the endophytes, including MD-b1, produce
the same bioactive compounds as their host plants, the fact that
the rare and important natural products may be readily available
and reproducible via fermentation would be noteworthy, as it may
preserve the world’s ever-diminishing biodiversity by reducing the
requirement for harvesting slow-growing plants. Therefore, the
present study provides a promising microbial source of high-value
products with significant therapeutic activities against gastric
tumors, thereby facilitating the natural product identification
process for new anticancer agents and benefiting anticancer
therapies in practice.
Acknowledgements
This study was financially supported
by two grants from the National Natural Science Foundation of China
(81173570 and 30973921) and the Subject of Zhejiang TCM
Administration Bureau (2006C019).
References
|
1
|
GLOBOCAN 2008 (IARC): Section of Cancer
Information WHO. http://www.who.int/mediacentre/factsheets/fs297/en/
Accessed July 20, 2012.
|
|
2
|
Gutierrez RM, Gonzalez AM and Ramirez AM:
Compounds derived from endophytes: a review of phytochemistry and
pharmacology. Curr Med Chem. 19:2992–3030. 2012. View Article : Google Scholar : PubMed/NCBI
|
|
3
|
Igarashi Y, Trujillo ME, Martínez-Molina
E, Yanase S, Miyanaga S, Obata T, Sakurai H, Saiki I, Fujita T and
Furumai T: Antitumor anthraquinones from an endophytic actinomycete
Micromonospora lupine sp, nov. Bioorg Med Chem Lett.
17:3702–3705. 2007. View Article : Google Scholar : PubMed/NCBI
|
|
4
|
Taechowisan TC, Lu CH, Shen YM and Lumyong
S: Antitumor activity of 4-Arylcoumarins from endophytic
Streptomyces aureofaciens CMUAc130. J Cancer Res Ther.
3:86–91. 2007. View Article : Google Scholar
|
|
5
|
Blunt JW, Copp BR, Hu WP, Munro MH,
Northcote PT and Prinsep MR: Marine natural products. Nat Prod Rep.
25:35–94. 2008. View
Article : Google Scholar
|
|
6
|
Hallmann J, Quadt-Hallmann A, Mahaffee WF
and Kloepper JW: Bacterial endophytes in agricultural crops. Can J
Microbiol. 43:895–914. 1997. View
Article : Google Scholar
|
|
7
|
Kobayashi DY and Palumbo JD: Bacterial
endophytes and their effects on plants and uses in agriculture.
Microbial Endophytes. Bacon CW and White JF Jr: Marcel Dekker; NY,
New York: pp. 199–233. 2000
|
|
8
|
Zinniel DK, Lambrecht P, Harris NB, Feng
Z, Kuczmarski D, Higley P, Ishmaru CA, Arunakumari A, Barletta RG
and Vidaver AK: Isolation and characterization of endophytic
colonizing bacteria from agronomic crops and prairie plants. Appl
Environ Microbiol. 68:2198–2208. 2002. View Article : Google Scholar : PubMed/NCBI
|
|
9
|
Azevedo JL, Maccheroni W Jr, Pereira JO
and Araújo WL: Endophytic microorganisms: a review on insect
control and recent advances on tropical plants. Electron J
Biotechnol. 3:e1–e4. 2000. View Article : Google Scholar
|
|
10
|
Sturz AV and Nowak J: Endophytic
communities of Rhizobacteria and the strategies required to create
yield enhancing associations with crops. Appl Soil Ecol.
15:183–190. 2000. View Article : Google Scholar
|
|
11
|
Lodewyck C, Vangronsveld J, Porteous F,
Moore ERB, Taghavi S, Mezgeay M and van der Lelie D: Endophytic
bacteria and their potential application. Crit Rev Plant Sci.
86:583–606. 2002. View Article : Google Scholar
|
|
12
|
Mundt JO and Hinkle NF: Bacteria within
ovules and seeds. Appl Environ Microbiol. 32:694–698.
1976.PubMed/NCBI
|
|
13
|
McInroy JA and Kloepper JW: Population
dynamics of endophytic bacteria in field-grown sweet corn and
cotton. Can J Microbiol. 41:895–901. 1995. View Article : Google Scholar
|
|
14
|
Cho KM, Hong SY, Lee SM, Kim YH, Kahng GG,
Lim YP, Kim H and Yun HD: Endophytic bacterial communities in
ginseng and their antifungal activity against pathogens. Microbial
Ecol. 54:341–351. 2007. View Article : Google Scholar : PubMed/NCBI
|
|
15
|
Tiwari R, Kalra A, Darokar MP, Chandra M,
Aggarwal N, Singh AK and Khanuja SP: Endohytic bacteria from
Ocimum sanctum and their yield enchancing capabilities. Curr
Micobiol. 60:167–171. 2010.
|
|
16
|
Vendan RT, Yu YJ, Lee SH and Rhee YH:
Diversity of endophytic bacteria in ginseng and their potential for
plant growth promotion. J Microbiol. 48:559–565. 2010. View Article : Google Scholar : PubMed/NCBI
|
|
17
|
Yu BY and Xu GJ: Studies on resource
utilization of Chinese drug Dwarf lilyturf (Ophiopogon
japonicus). J Chin Herbs. 26:205–210. 1995.
|
|
18
|
Xiao PG: Modern Chinese Materia Medica.
Chemical Indestry Press; Beijing: pp. 772002
|
|
19
|
Kou J, Yu B and Xu Q: Inhibitory effects
of ethanol extract from Radix Ophiopogon japonicus on venous
thrombosis linked with its endothelium-protective and anti-adhesive
activities. Vascul Pharmacol. 43:157–163. 2005.PubMed/NCBI
|
|
20
|
Zhou YF, Qi J, Zhu DN and Yu BY: Two new
steroidal glycosides from Ophiopogon japonicus. Chin Chem
Lett. 19:1086–1088. 2008. View Article : Google Scholar
|
|
21
|
China Pharmacopoeia Committee:
Pharmacopoeia of the People’s Republic of China. China Chemical
Industry Press; I. Beijing, China: 64. 2010
|
|
22
|
Kou J, Sun Y, Lin Y, Cheng Z, Zheng W, Yu
B and Xu Q: Anti-inflammatory activities of aqueous extract from
Radix Ophiopogon japonicus and its two constituents. Biol
Pharm Bull. 28:1234–1238. 2005. View Article : Google Scholar : PubMed/NCBI
|
|
23
|
Lin X, Xu DS, Feng Y, Li SM, Lu ZL and
Shen L: Release-controlling absorption enhancement of enterally
administered Ophiopogon japonicus polysaccharide by sodium
caprate in rats. J Pharm Sci. 95:2534–2542. 2006. View Article : Google Scholar : PubMed/NCBI
|
|
24
|
Li N, Zhang JY, Zeng KW, Zhang L, Che YY
and Tu PF: Anti-inflammatory homoisoflavonoids from the tuberous
roots of Ophiopogon japonicus. Fitoterapia. 83:1042–1045.
2012. View Article : Google Scholar : PubMed/NCBI
|
|
25
|
Wang LY, Wang Y, Xu DS, Ruan KF and Wang
S: MDG-1, a polysaccharide from Ophiopogon japonicas exerts
hypoglycemic effects through the PI3K/Akt pathway in a diabetic
KKAy mouse model. J Ethnopharmacol. 143:347–354. 2012.PubMed/NCBI
|
|
{
label needed for ref[@id='b26-ol-05-06-1787']
}
|
[26] Koyama R,
Matsumoto A, Inahashi Y, Ōmura S and Takahashi Y: Isolation of
actinomycetes from the root of the plant, Ophiopogon
japonicus, and proposal of two new species, Actinoallomurus
liliacearum sp nov and Actinoallomurus vinaceus sp nov.
J Antibiot (Tokyo). 65:335–340. 2012.PubMed/NCBI
|
|
27
|
Rosenblueth M and Martinez-Romero E:
Rhizobium etli maize populations and their competitiveness
for root colonization. Arch Microbiol. 181:337–344. 2004.
View Article : Google Scholar
|
|
28
|
Chen YT, Ding LX, Cheng DQ, Ding ZS, Lin
MA and Pan PL: Isolation and identification of endofungi from
Liriope spicata. J Laiyang Agri Col (Nat Sci). 23:13–16.
2006.(In Chinese).
|
|
29
|
Miller KI, Qing C, Sze DM and Neilan BA:
Investigation of the biosynthetic potential of endophytes in
traditional Chinese anticancer herbs. PLoS One. 7:e359532012.
View Article : Google Scholar : PubMed/NCBI
|
|
30
|
Rosenblueth M and Martínez-Romero E:
Bacterial endophytes and their interactions with hosts. Mol Plant
Microbe Interact. 19:827–837. 2006. View Article : Google Scholar : PubMed/NCBI
|
|
31
|
Compant S, Mitter B, Colli-Mull JG, Gangl
H and Sessitsch A: Endophytes of grapevine flowers, berries, and
seeds: identification of cultivable bacteria, comparison with other
plant parts, and visualization of niches of colonization. Microbial
Ecol. 62:188–197. 2011. View Article : Google Scholar
|
|
32
|
Bonmatin J, Laprévote O and Peypoux F:
Diversity among microbial cyclic lipopeptides: iturins and
surfactins. Activity-structure relationships to design new
bioactive agents. Comb Chem High Throughput Screen. 6:541–556.
2003. View Article : Google Scholar
|
|
33
|
Snook ME, Mitchell T, Hinton DM and Bacon
CW: Isolation and characterization of leu7-surfactin from the
endophytic bacterium Bacillus mojavensis RRC 101, a
biocontrol agent for Fusarium verticillioides. J Agric Food
Chem. 57:4287–4292. 2009. View Article : Google Scholar : PubMed/NCBI
|
|
34
|
Krishnan P, Bhat R, Kush A and Ravikumar
P: Isolation and functional characterization of bacterial
endophytes from Carica papaya fruits. J Appl Microbiol.
113:308–317. 2012. View Article : Google Scholar : PubMed/NCBI
|
|
35
|
Newman DJ and Cragg GM: Natural products
as sources of new drugs over the last 25 years. J Nat Prod.
70:461–477. 2007.PubMed/NCBI
|
|
36
|
Strobel G, Daisy B, Castillo U and Harper
J: Natural products from endophytic microorganisms. J Nat Prod.
67:257–268. 2004. View Article : Google Scholar : PubMed/NCBI
|
|
37
|
Yang MP, Wu H, Yin L, Zhang X and Duan JA:
Advances in research of saponins and polysaccharides in
Ophiopogonis japonicus. Chin Arch Trad Chin Med.
10:2169–2171. 2008.
|
|
38
|
Chen YT, Lu QY, Lin MA, Cheng DQ, Ding ZS
and Shan LT: A PVP-extract fungal protein of Omphalia
lapideacens and its antitumor activity on human gastric tumors
and normal cells. Oncol Rep. 26:1519–1526. 2011.PubMed/NCBI
|
|
39
|
Xia M, Huang R, Witt KL, Southall N,
Fostel J, Cho MH, Jadhav A, Smith CS, Inglese J, Portier CJ, Tice
RR and Austin CP: Compound cytotoxicity profiling using
quantitative high-throughput screening. Environ Health Perspect.
116:284–291. 2008. View Article : Google Scholar : PubMed/NCBI
|
|
40
|
Chiu TH, Lai WW, Hsia TC, Yang JS, Lai TY,
Wu PP, Ma CY, Yeh CC, Ho CC, Lu HF, Wood WG and Chung JG:
Aloe-emodin induces cell death through S-phase arrest and
caspase-dependent pathways in human tongue squamous cancer SCC-4
cells. Anticancer Res. 29:4503–4511. 2009.PubMed/NCBI
|
|
41
|
Zheng JY, Tao LY, Liang YJ, Chen LM, Mi
YJ, Zheng LS, Wang F, She ZG, Lin YC, To KK and Fu LW:
Anthracenedione derivatives as anticancer agents isolated from
secondary metabolites of the mangrove endophytic fungi. Mar Drugs.
8:1469–1481. 2010. View Article : Google Scholar : PubMed/NCBI
|
|
42
|
Tan RX and Zou WX: Endophytes: a rich
source of functional metabolites. Nat Prod Rep. 18:448–459.
2001.PubMed/NCBI
|
|
43
|
Thompson JD, Higgins DG and Gibson TJ:
CLUSTAL W: improving the sensitivity of progressive multiple
sequence alignment through sequence weighting, position-specific
gap penalties and weight matrix choice. Nucleic Acids Res.
22:4673–4680. 1994. View Article : Google Scholar
|
|
44
|
Thompson JD, Gibson TJ, PleWniak F,
Jeanmougin F and Higgins DG: The CLUSTAL_X windows interface:
flexible strategies for multiple sequence alignment aided by
quality analysis tools. Nucleic Acids Res. 25:4876–4882. 1997.
View Article : Google Scholar : PubMed/NCBI
|
|
45
|
Tamura K, Dudley J, Nei M and Kumar S:
MEGA4: Molecular Evolutionary Genetics Analysis (MEGA) software
version 4.0. Mol Biol Evol. 24:1596–1599. 2007. View Article : Google Scholar : PubMed/NCBI
|
|
46
|
Saitou N and Nei M: The neighbor-joining
method: a new method for reconstructing phylogenetic trees. Mol
Biol Evol. 4:406–425. 1987.PubMed/NCBI
|
|
47
|
Felsenstein J: Evolutionary trees from DNA
sequences: a maximum likelihood approach. J Mol Evol. 17:368–376.
1981. View Article : Google Scholar : PubMed/NCBI
|
|
48
|
Fitch WM: Toward defining the course of
evolution: minimum change for a specific tree topology. Syst Zool.
20:406–416. 1971. View Article : Google Scholar
|
|
49
|
Masuko T, Minami A, Iwasaki N, Majima T,
Nishimura S and Lee YC: Carbohydrate analysis by a phenol-sulfuric
acid method in microplate format. Anal Biochem. 339:69–72. 2005.
View Article : Google Scholar : PubMed/NCBI
|
|
50
|
Tang QY and Feng MG: DPS Data Processing
System: Experimental Design, Statistical Analysis, and Data Mining.
Science Press; Beijing: pp. 146–164. 2007
|